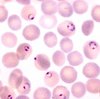

Blood Parasites Flashcards
(36 cards)
Parasites
In the broad sense of the term, any pathogen is a “parasite” as it lives at the expense of the host. The more narrow meaning of the term “parasite” refers to pathogens that are eukaryotes, but not fungi.
A large number of adults in the United States are infected with the protozoan ____.
A large number of adults in the United States are infected with the protozoan Toxoplasma gondii
Protozoa
One-celled eukaryotes.
For protozoa that serve as parasites, transmission from one host to another usually depends on arthropod vectors.
An alternative strategy used by some protozoa is to alternate between two distinct forms: an active trophozoite form that grows and replicates by binary fission with the host, and a dormant, nonreplicating cyst form that is adapted for survival in various environmental extremes as it transits between hosts.
Helminths of medical importance
Roundworms, flatworms (also called flukes) and tapeworms
Malaria
Caused by five species of Plasmodium: P. falciparum, P. vivax, P. ovale, P. malariae and P. knowlesi. Blood parasites. Has a complex life cycle, resulting in cycles of fever, chills, and anemia.
48 hour cycle: P. vivax or P. ovale
72 hour cycle: P. malariae
Irregular: P. falciparum
Plasmodium-mediated disease
Symptoms ~8-30 days after infection. Cycles of fever, chills, anemia, nausea, diarrhea, vomitting. Synchronized lysing of erythrocytes. Affects liver, then erythrocytes. Anemia results from erythrocyte lysis.
Length of malaria cycle vs species
48 hour cycle: P. vivax or P. ovale
72 hour cycle: P. malariae
Irregular: P. falciparum
Plasmodium life cycle

Plasmodium-mediated damage (based on life cycle alone)
- Sporozoites are injected into the human bloodstream when infected mosquitoes bite and feed.
- Organisms enter hepatocytes within 30 minutes of injection (hepatocellular cycle)
- Merozoites are released from liver and infect erythrocytes
- After 2-3 days erythrocytes burst and produce new merozoites (erythrocytic cycle)
- A minority of the merozoites in the blood develop into forms capable of sexual reproduction (gametocytes)
- Gametocytes are taken up by biting mosquitoes, where they fuse in sexual reproduction
- Parasite develops in mosquito and spreads to salivary glands where they may produce new infections.
Plasmodium-mediated damage (aside from life cycle)
- Coordinated erythrocyte lysis produces many DAMPs which activate production of IL-1 and TNF-α, resulting in systemic acute fever.
- Malaria may cause splenomegaly, and splenectomized patients have higher degrees of parasitemia and more severe infections
- P. falciparum invades erythrocytes of all ages
- P. falciparum causes the red blood cells to bind to the vascular endothelium, potentially resulting in ischemia (pfEMP-1 - ICAM-1)
- pfEMP-1 is encoded by var genes. Each genome contains ~60 var genes and there are over 30,000 total known. This makes it impossible for the immune system to consistently respond.
- P. vivax and P. ovale create hypnozoites in the liver, which serve as a dormant source of infection
Relative virulence of Plasmodium species
Plasmodium falciparum is much more virulent than the other species
Diagnosis of malaria
- Giemsa-stained smear of peripheral blood (may even differentiate species)
- Rapid antigen detection tests
- PCR
Serologic testing is of little value, as acutely ill patients are ill 3-5 weeks before they develop an antibody response.
Ring stage Plasmodium in erythrocytes
Natural immunity to malaria is. . .
. . . imperfect. People in endemic areas have some resistance, but not complete resistance.
Treatment of Malaria
Chloroquine was once the most widely used drug for antimalarial chemoprophylaxis and treatment. Unfortunately, chloroquine-resistant P. falciparum are now widespread in most of Southeast Asia, South America, and Africa.
Patients infected with chloroquineresistant P. falciparum can be treated with other agents, such as Malarone (a fixed combination of atovaquone and proguanil), Coartem (a fixed combination of artesunate and lumefantrine), quinine plus doxycycline, or quinidine.
None of the above are effective against the P. ovale and P. vivex hypnozoites, but primaquine is effective against dormant malaria, and is often given to prevent relapse.
Recommended treatment of acute malaria?
Of dormant malaria?
Acute: Malarone
Dormant: Primaquine
Prevention of Malaria
Mosquito nets, mosquito nets, mosquito nets
Plus insecticides and draining of stagnant water
Babesia
- Babesia* species are protozoal parasites that cause illness by infecting red blood cells and generating fever on release. Unlike malaria, babesiosis is endemic in the United States. It occurs primarily in the Northeast and upper Midwest.
- Babesia microti* is the common cause of human babesiosis in the United States.
Source of Babesia infection
Babesia is transmitted to humans by Ixodes ticks (which can also transmit Lyme disease). The animal reservoir for Babesia is the white footed mouse.
Human infection can also occur through blood transfusion and, rarely, through organ transplantation.
Humans are a dead-end host.
Babesia-mediated disease
Babesiosis is difficult to recognize clinically because the illness it causes is nonspecific. Infected persons experience a flulike illness, with fever, chills, sweats, muscle aches, and fatigue.
Illness is usually mild, but more severe disease occurs in splenectomized patients. As in malaria, the spleen is thought to remove the Babesia-infected red blood cells from the circulation.
Babesiosis in erythrocytes

Treatment of Babesiosis
Babesia infections are treated with different chemotherapeutic agents than malaria: azithromycin and atovaquone or clindamycin plus quinine.
Toxoplasma gondii
Disseminates widely in the human host and can be found in a variety of tissues. Usually very benign or completely asymptomatic, except in immunocompromised individuals. Specifically, occurs very frequently in AIDS or late stage HIV patients.
Source of Toxoplasma infection
- Eating inadequately cooked meat
- Ingesting infectious oocytes found in cat feces
